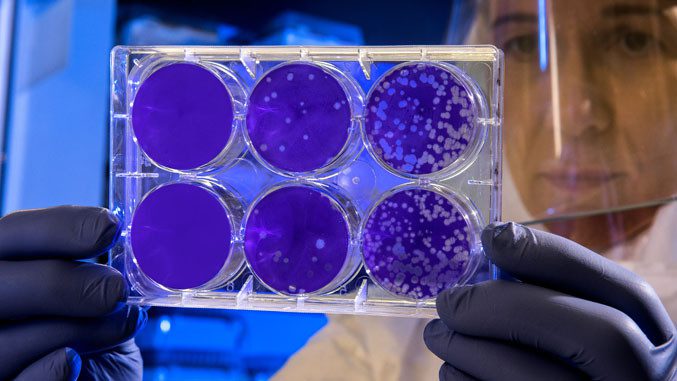

Smanjiti zagađenje izazvano farmaceutskim i poljoprivrednim sektorom ključno je u borbi protiv širenja superbakterija koje su otporne na lekove. Ove bakterije mogle da izazovu da do 2050. godine godišnje od nje strada do 10 miliona ljudi.
„Sve je jasnije da okolina igra ključnu ulogu u razvoju, prenosu i širenju”, otpornosti antimikroba (AMR), ističe UN u svome izveštaju.
Ta otpornost razvija se kada mikroorganizmi kao što su bakterije, virusi, paraziti ili gljivice postaju otporni na antimikrobne terapije na koje su ranije bili osetljivi, piše Indeks. Svetska zdravstvena organizacija smatra antibiootpornost pretnjom i strahuje da se svet kreće prema dobu u kojem će svakodnevne infekcije ponovno početi da ubijaju. UN procenjuje da je 1,27 miliona smrti u 2019. godini bilo povezano sa infekcijama otpornim na lekove, a do 2050. godine ta brojka bi mogla da naraste na 10 miliona novih smrti na godišnjem nivou.
Ovakvu vrstu otpornosti podstiče i preterana primena antibiotika, ali UN ističe i da je otpornost „tesno povezana sa trostrukom krizom naše planete: klimatskom krizom, gubitkom bioraznolikosti i prirodnih staništa te zagađenjem i otpadom”. Zagađenje, posebno povezano sa farmaceutskom industrijom i poljoprivredom, omogućava zapravo antimikrobima da uđu u okolinu, najbrže u reke.
„To je istinski problem jer su reke često izvor naše pitke vode”, ističe mikrobiolog Džonaton Koks sa britanskog Univerziteta Aston.
„Možemo već govoriti o tihoj pandemiji”, kaže Koks, a UN predlaže sklop rešenja koja ciljaju sektore koji povećavaju taj problem. Tako bi bolnice morale da ugrade specifične načine za pročišćavanje korišćenih voda, da garantuju trajno uništenje lekova, dok u poljoprivredi treba da se zaštitite vode.